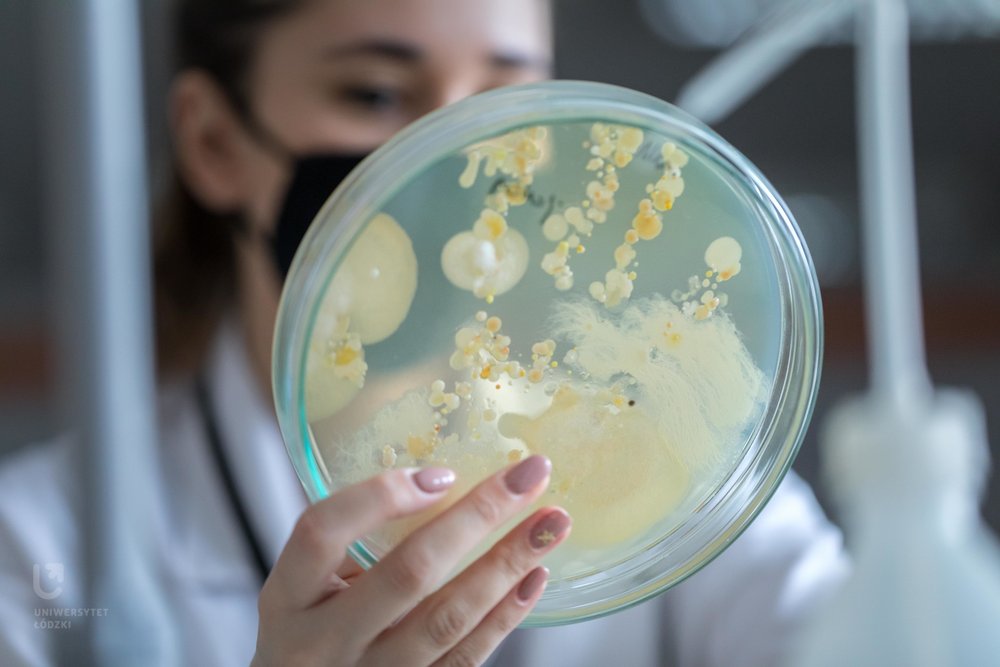

W trakcie tegorocznej Nocy Biologów można było posłuchać trzech wykładów o tematyce popularno-naukowej oraz wziąć udział w trzech warsztatach/pokazach, których tematem przewodnim był "Człowiek i mikroorganizmy".
- Uczestnicy akcji dowiedzieli się m.in. na czym polega bioterroryzm, jak wygląda ekscytujący związek pomiędzy mikroskopijnymi grzybami a innymi organizmami i który z partnerów odnosi większe korzyści w tej, czasami skomplikowanej, przyjaźni oraz jak sinice, znane głównie z uciążliwych zakwitów na kąpieliskach, można wykorzystać w medycynie. Nie zabrakło też atrakcji naukowych dla tych, którzy lubią zajęcia praktyczne: można było m.in. w relacji na żywo z laboratorium obejrzeć mikroorganizmy prosto spod mikroskopu, dowiedzieć się, gdzie w naszym otoczeniu szukać mikrobów i w jaki sposób nawiązać z nimi przyjacielskie relacje oraz jak przygotować domowe kosmetyki o właściwościach przeciwbakteryjnych i przeciwgrzybiczych - wymienia dr Anita Ciesielska, Koordynator Nocy Biologów.
W wykładach oraz warsztatach/pokazach wzięło udział ponad 200 uczestników.

Noc Biologów 2021, fot. M. Andrzejewski, CP UŁ
- Przestrzeń wirtualna pozwoliła na prezentację naszej oferty wszystkim zainteresowanym w całej Polsce. Zgromadziliśmy uczestników z Łodzi i okolicy, ale również z Torunia, Sokołowa Podlaskiego, Krakowa, Katowic, Warszawy, Dąbrowy Górniczej i Elbląga - dodaje dr A. Ciesielska.
Kolejna edycja "Nocy Biologów" już za rok. Dla Wydziału Biologii i Ochrony Środowiska UŁ będzie to jubileuszowa 10. edycja.
Noc Biologów to impreza naukowa, mająca charakter przede wszystkim edukacyjny, a jej celem jest upowszechnianie wiedzy przyrodniczej wśród odbiorców ze wszystkich grup wiekowych.
Uniwersytet Łódzki to jedna z największych polskich uczelni. Misją UŁ jest kształcenie wysokiej klasy naukowców i specjalistów w wielu dziedzinach humanistyki, nauk społecznych, przyrodniczych, ścisłych, nawet medycznych. UŁ współpracuje z biznesem, zarówno na poziomie kadrowym, zapewniając wykwalifikowanych pracowników, jak i naukowym, oferując swoje know-how przedsiębiorstwom z różnych gałęzi gospodarki. Uniwersytet Łódzki jest uczelnią otwartą na świat - wciąż rośnie liczba uczących się tutaj studentów z zagranicy, a polscy studenci, dzięki programom wymiany, poznają Europę, Azję, wyjeżdżają za Ocean. Uniwersytet jest częścią Łodzi, działa wspólnie z łodzianami i dla łodzian, angażując się w wiele projektów społeczno-kulturalnych.
Zobacz nasze projekty naukowe na https://www.facebook.com/groups/dobranauka/https://www.facebook.com/groups/dobranauka/
https://www.facebook.com/groups/dobranauka/
Materiał: WBiOŚ UŁ
Redakcja: Centrum Promocji UŁ